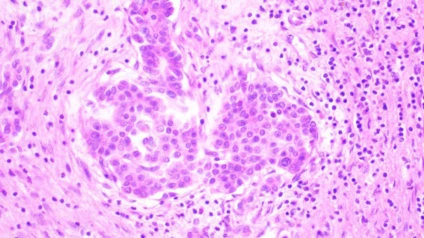
TRINOKULYAR MIKROSKOP Raqamli kamera va LCD monitorli BS-2046T

Bosh sahifa / Tibbiy asbob-uskunalar / Optik qurilmalar va tizimlar / Mikroskoplar / TRINOKULYAR MIKROSKOP Raqamli kamera va LCD monitorli BS-2046T
TRINOKULYAR MIKROSKOP Raqamli kamera va LCD monitorli BS-2046T
AsosiyTa'rifO‘xshash takliflarBoshqa korxonalardan o'xshash takliflarKo‘rilgan mahsulotlarFikr-mulohazalar

Mahsulotning ko'rinishi saytdagi rasmdan farq qilishi mumkin
Mahsulot haqida tafsilotlar
Ishlab chiqarilgan joyi:Xitoy
Kategoriya:Mikroskoplar
Bor
26 000 000 so'm / dona

DENIS MED
O'zbekiston,
Ta'rif
Производитель: Bestscope International Limited (Китай)
- Цифровая Камера модель BLC-280: 8 Мп
- Сенсор: Sony IMX415 (C) 1/2.8"(5.57x3.13)
- LCD экран: HD1080P133A
- Вывод данных: USB 2.0, HDMI
- Оптическая система: Бесконечная оптическая система NIS
- Сохранение изображения и видео на SD-карту (8Гб)
- Окулярный тубус: Тринокулярный Seidentopf, наклон 30°, межзрачковое расстояние 47-78 мм, обе окулярные трубки с диоптрийной регулировкой
- Окуляр: Широкоугольный окуляр WF10× / 20 мм
- Ахроматические объективы на 4х, 10х,40х,100х (масло)
- Освещение: 3W LED лампа, регулируемая яркость
- Предметный столик: 180х130 мм, диапазон вращения 74х30 мм
- Конденсор: Выдвижной центрируемый, числовая апертура 1.20
- Фокусировочная система: коаксиальные рукоятки грубой и точной фокусировки
Вес: 9 кг
DENIS MEDdan o'xshash takliflar
Boshqa korxonalardan o'xshash takliflar
Ko‘rilgan mahsulotlar
Fikr-mulohazalar
Reyting 0, 0 ta sharh asosida











